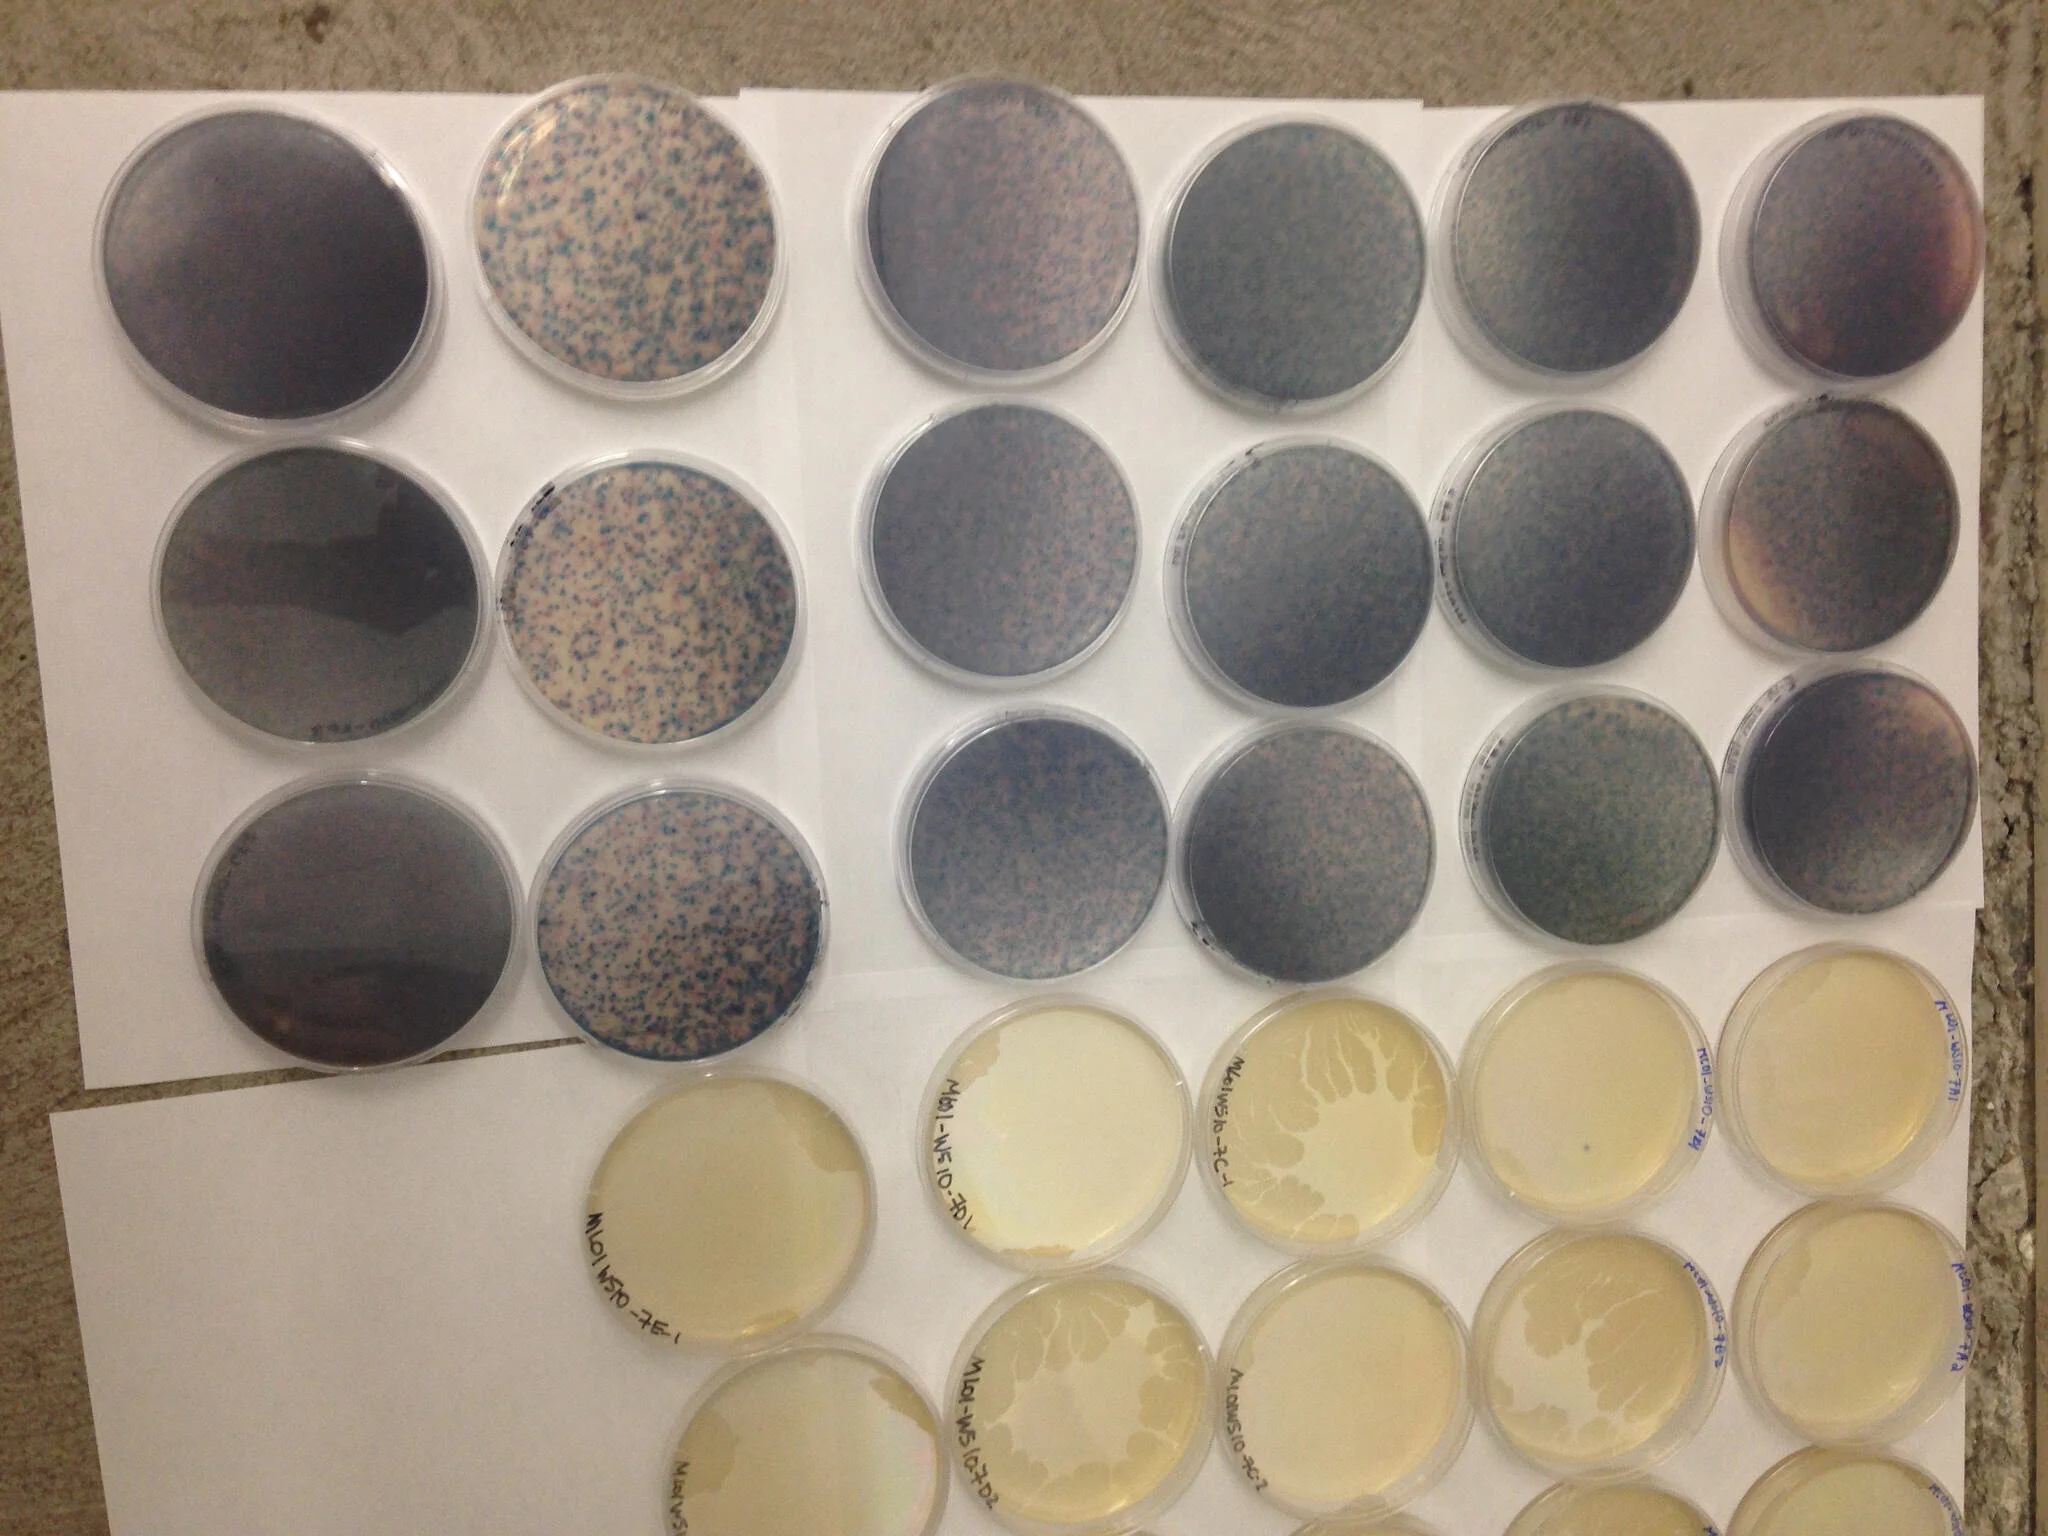

Swim Drink Fish
Stories
Read the latest stories, updates and news releases about community science, water monitoring, and more.

Report urges Canadian and US governments to do more to protect the Great Lakes
The International Joint Commission releases final report urging the Canadian and US governments to do more to protect the Great Lakes—with emphasis on improving and protecting swimmable, drinkable, fishable water.

Kingston launches really cool sewage overflow alerts website
Kingston becomes the first municipality in Ontario to provide real-time alerts for sewage overflows.
Whatever happened to Toronto sewage alerts?
In August 2015, Waterkeeper announced that Toronto residents would soon receive alerts when wet weather sends sewage and stormwater into Lake Ontario. It’s now May 2017. It rained hard last week. Bacteria in the Toronto Harbour spiked. So what's happening? When can you expect to see those wet weather alerts?

Case Update: What’s happening in Toronto Harbour
Samples taken from Toronto Harbour this spring have been the "worst we've ever seen." Learn more about the results and just how much higher they are than accepted government standards.

A close look at flushability standards (or the lack thereof)
Don't let labels fool you, there are no such things as "flushable" wipes. Learn more about the push to set official flushability standards and what can be done in the meantime.

Results are in: Reporting on Toronto Harbour’s water quality and sewage pollution
Yesterday, Waterkeeper's VP Krystyn Tully presented our much-anticipated Toronto Harbour Report to a room filled with boaters, paddlers, surfers, swimmers, and water lovers from around the city. Attendees watched as all of our findings were revealed in our video report, which will be published online in December. In case you weren't able to attend, here is a sneak peek.
Lake Ontario Waterkeeper and Swim Guide sign on to Public Notification for CSOs in the Great Lakes
On September 23, 2016, Waterkeepers of the Great Lakes Region, including Lake Ontario Waterkeeper and Swim Guide, signed onto comments for the “Public Notification for Combined Sewer Overflows in the Great Lakes."
For Media
